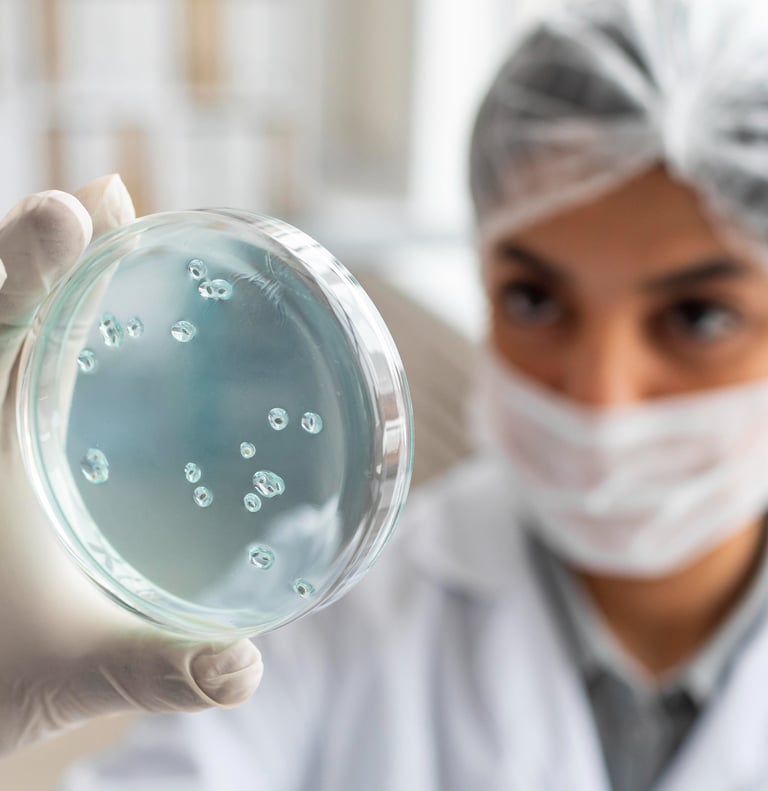
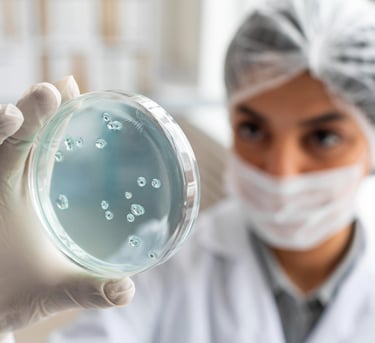

Lactobacillus rhamnosus GG
Lactobacillus rhamnosus GG yra labiausiai žinoma ir plačiausiai ištirta probiotinių bakterijų padermė. Šiuo metu ji turi didžiausią saugos įvertinimą iš bet kurios kitos probiotikų padermės.
Keli atsitiktinių imčių kontroliuojami tyrimai ir metaanalizės parodė, kad Lactobacillus rhamnosus GG tiek suaugusiems, tiek vaikams mažina viduriavimo trukmę, slopina sunkumą atsiradusį dėl rotavirusinės infekcijos ir gydymo antibiotikais. Šios bakterijos gali užkirsti kelią vaikų hospitalinėms ir žarnyno infekcijoms, taip pat veikti kaip adjuvantas gydant funkcinį pilvo skausmą, sumažinant dirgliosios žarnos simptomų dažnumą ir sunkumą. Lactobacillus rhamnosus GG garantuoja žarnyno veiklos optimizavimą tiek normaliomis sąlygomis, tiek esant disbalanso veiksniams, tokiems kaip viduriavimo sindromai ar gydymas antibiotikais.


LACTOBACILLUS RHAMNOSUS GG NAUDA

Europos vaikų gastroenterologijos hepatologijos ir mitybos draugija (ESPGHAN) 2023 m. vasario mėn. pranešime „Probiotikai vaikų virškinamojo trakto ligoms gydyti“ buvo nustatytos tik dvi padermės, kurios yra veiksmingos gydant ūminį gastroenteritą ir antibiotikų sukeltą viduriavimą, viena iš dviejų padermių yra Lactobacillus rhamnosus GG. Pranešimo dokumente Lactobacillus rhamnosus GG padermė taip pat yra išskirta dėl veiksmingos prevencijos ankstukų nekrotizuojančiam enterokolitui ir hospitalinėms infekcijoms¹⁵.
Toksikologiniai ir klinikiniai tyrimai patvirtino¹³⁻¹⁴ Lactobacillus rhamnosus GG saugumą. Įprastas mitybos papildymas, šiomis bakterijomis, 6 metų vaikų grupei, kurie gimė labai mažo svorio, pasirodė esąs mikrobiologiškai saugus ir kliniškai gerai toleruojamas¹⁴.
Lactobacillus rhamnosus GG vartojimas yra naudingas ne tik esant patologinėms būklėms, tokioms kaip viduriavimas, uždegiminės žarnyno ligos, atopinis dermatitas ar gydymas antibiotikais, bet padeda atkurti vidinę imuninės sistemos pusiausvyrą, stimuliuoja imuninį atsaką prieš išorinius biologinius ir aplinkos patogenus, atkuria mikroorganizmų pusiausvyrą ir subalansuoja floros sudėtį, skatinančią daug fiziologinių funkcijų būtinų gerai organizmo veiklai.
Manoma, kad ilgesnį laiką vartojant Lactobacillus rhamnosus GG rekomenduojamomis dozėmis, bakerijų kolonijos stimuliuoja gleivinės imuninę sistemą žarnyno lygmeniu, skatina specifinių antikūnų (IgA) gamybą ir normalizuoja žarnyno pralaidumą. Jos taip pat gali gaminti specifinius antimikrobinius komponentus, kurie daro tiesioginį poveikį patogenams.

